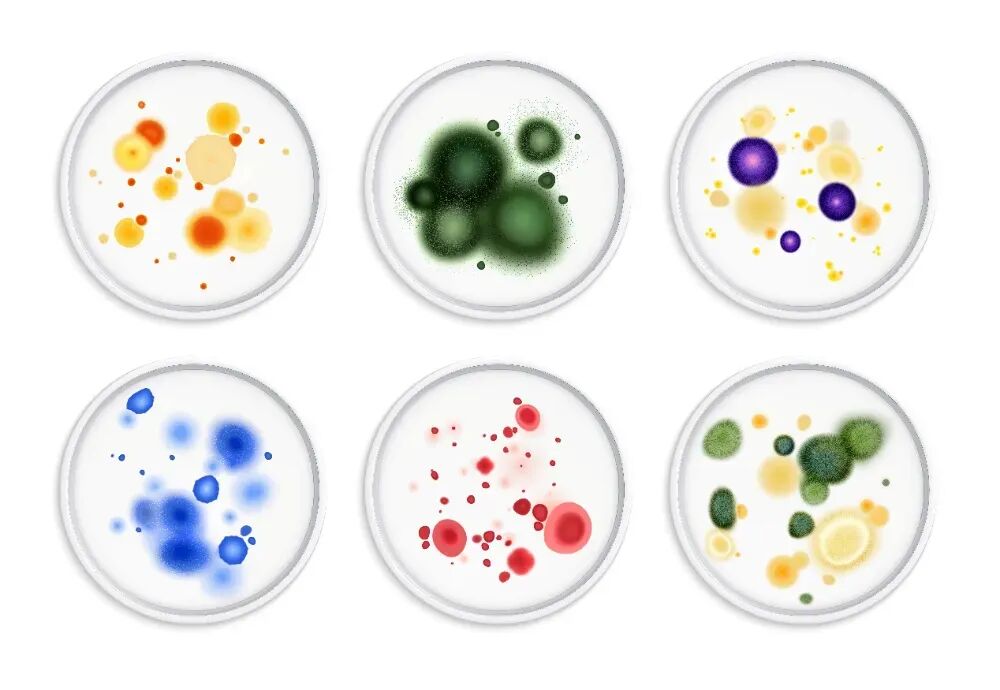

现实版“植物大战僵尸”?6岁女童发烧17天脑子险被吃掉
来源:CHTV百姓健康2026-01-27 20:42:34
近日,河南郑州一名 6 岁女童持续发烧 17 天,伴随意识不清,被紧急转院治疗。医生检查后发现了令人心惊的一幕:孩子的脑部竟被 “啃” 出大大小小十几个洞,若再延误几天,脑部组织可能被彻底 “啃空”!抽取洞内积液检测后,医生最终锁定 “真凶”—— 烟曲霉菌。
医生介绍,烟曲霉菌常潜伏在潮湿环境中,孩子在这类环境玩耍后,霉菌孢子通过呼吸道进入体内,随血液循环扩散,最终 “爬” 进脑部引发严重感染。这起悲剧也给所有人敲响警钟:家中潮湿角落的霉菌,可能藏着致命风险,日常务必做好通风和除霉工作。
烟曲霉菌是日常生活中最常见的曲霉菌之一,广泛存在于土壤、空气及谷物等食品中,肉眼可见的形态,就是物品表面灰绿色、蓝绿色的毛茸茸霉点。它的生命力极强,在超过 20℃的温暖环境中就能快速繁殖,即便在 37℃甚至 45℃的高温下也能正常生长,室温环境中 3 天即可成熟扩散,形成粉末状或绒毛状的菌落。
烟曲霉菌虽外表不起眼,致病性却极强。它在曲霉属中致病性名列前茅,尤其对免疫力低下人群威胁极大。它的孢子会随空气漂浮,被人体吸入后先定植在呼吸道、耳道等部位,一旦人体受外伤或免疫力下降,这些孢子就会趁机大量繁殖,侵袭肺、眼、脑、骨骼等多个器官,引发严重感染。
其中,侵袭性肺曲霉病是最常见的类型,会在肺部形成曲霉球,破坏肺部组织;同时还可能诱发过敏性肺支气管曲霉病,引发哮喘样症状。更危险的是,它可能通过血液播散至颅内、骨骼,引发致命性感染,这类侵袭性感染病情进展极快,在免疫力低下人群中病死率相对较高。临床上通常采用米卡芬净、伊曲康唑、泊沙康唑等抗真菌药物进行治疗。
自然界中曲霉菌种类繁多,除烟曲霉外,还有黄曲霉、黑曲霉等。对免疫系统健全的健康人来说,吸入少量曲霉菌孢子通常不会致病,身体能自行清除,最多出现轻微过敏反应;但过敏体质者、哮喘患者、囊性纤维化(一种遗传性呼吸系统疾病)患者,以及老人、儿童、慢性病患者等免疫力低下人群,感染风险会显著升高。
曲霉菌感染的症状十分不典型,与肺炎、肺结核表现相似,很容易被误诊延误病情。常见症状包括持续咳嗽、咳痰、发热、胸闷、胸痛、气急、呼吸困难,严重时还会出现咯血。医生提醒:若免疫力低下人群出现不明原因发热、下呼吸道感染症状,经广谱抗生素治疗后无好转,需警惕曲霉菌感染,务必及时就医明确诊断。
家中的霉点绝不止影响美观,还会从多方面危害人体健康,部分霉菌甚至具有致癌风险,比如黄曲霉菌分泌的黄曲霉毒素,就属于一类致癌物。
黑曲霉常附着在潮湿的淋浴间、洗漱台周围,易侵袭老人、儿童等免疫力较弱人群,诱发呼吸系统疾病;瓜枝孢则多漂浮在空气中或附着于墙面,是哮喘发作的重要诱因。而烟曲霉更是被世界卫生组织列入首份真菌 “重点病原体” 清单,对免疫力低下者可引发致命性肺部感染,腐烂落叶、潮湿土壤中都可能附着其孢子。
霉菌是重要的过敏原,其产生的孢子体积微小、易漂浮扩散,被过敏体质者吸入后,会引发眼睛发红发痒、皮肤瘙痒、鼻塞、咳嗽等症状。北京同仁医院对门诊过敏性鼻炎患者的统计显示,霉菌是重要致病原因之一,且在夏季潮湿环境中更为活跃。
霉菌还可能侵入消化道,比如念珠菌就可能引发食道炎、胃肠炎,导致腹痛、腹泻、恶心等不适,尤其对儿童和老人的肠胃伤害更为明显。
霉菌繁殖需满足四个条件:温度超过 20℃、湿度高于 70%、有垃圾 / 灰尘提供 “营养”、氧气充足。结合这些特性,家中以下 5 个角落最易成为霉菌 “温床”,需重点防范:
■ 卫生间及浴室:墙角、瓷砖缝、水龙头、浴室帘、密封胶等处最易发霉。建议加装排风扇并经常使用,洗澡后先用热水冲刷墙面、浴缸,再用冷水冲洗,及时拖干地面水渍,保持干燥。
■ 冰箱:密封条、底座及内部易滋生链格孢霉菌,引发吸入性过敏;带土蔬菜存放时,泥土中的霉菌还会污染其他食材。建议每月清洗一次冰箱,重点擦洗密封条,生熟食材分开存放,避免冰箱内过度拥挤。
■ 洗衣机:洗好的衣服未及时取出、用完后紧闭机盖,会给霉菌繁殖创造条件。建议定期用专用清洗剂清洁内筒并消毒,梅雨季需加强清洁频率。
■ 菜板:木制、竹制菜板若清洗不彻底、水分残留,极易发霉。建议用完后及时擦干,餐后尽快清理厨余垃圾,避免食物残渣残留滋养霉菌。
■ 卧室及阳台:阳台养花、晾衣易导致角落潮湿发霉;空调内部湿气积聚、床垫因人体夜间出汗受潮,也会滋生霉菌。建议空调使用前先清洗,寝具定期暴晒、通风,潮湿天气开启空调除湿模式。
温暖潮湿是霉菌滋生的核心条件,日常做好清洁、干燥防护,同时提升自身免疫力,就能有效降低感染风险:
■ 保持环境清洁:重点清洁厨房、浴室、床底、柜子角落等潮湿、易积灰区域,及时清理垃圾和食物残渣,不给霉菌提供 “营养”。
■ 坚持通风换气:每天定时开窗通风,促进空气流通,降低室内湿度和空气中霉菌孢子浓度,尤其阴雨天气后需加强通风。
■ 保持储物干燥:衣柜、橱柜、书柜等储物空间,可放置干燥剂吸收湿气,避免衣物、书籍受潮发霉,进而滋生霉菌。
■ 提升自身免疫力:老人、儿童、慢性病患者等高危人群,需保持均衡饮食、适度运动、充足睡眠,增强身体抵抗力,抵御霉菌侵袭。
霉菌可通过高温(80℃以上水温、阳光暴晒等)、按说明书稀释的家用 84 消毒液(建议 1:10 兑水)等方式杀灭,注意 84 消毒液不可与洁厕灵等清洁剂混用,避免产生有毒气体。
针对不同场景,除霉方法有差异:墙体霉点较轻微时,可用抹布直接擦拭,或喷稀释后的漂白水(1:10 兑水,彩色墙面慎用);如为墙纸,不能用水擦,要用浸有 75% 医用酒精的抹布轻拭。温馨提示:除霉时务必佩戴手套、口罩,保持开窗通风,避免吸入霉菌孢子引发不适。
6 岁女童的悲剧,让我们看清了潮湿环境中霉菌的致命威力 —— 那些被我们忽视的墙角霉点、衣物潮味,可能藏着侵袭身体的 “隐形杀手”。霉菌的危害从不是小题大做,尤其是对老人、儿童等免疫力较弱的群体,一次疏忽就可能引发难以挽回的后果。
生活中的健康防线,往往藏在细节里。勤开窗、保持干燥、及时除霉、增强体质,这些看似简单的举动,正是抵御霉菌感染的关键。愿我们都能重视家中的潮湿隐患,做好日常防护,用细微的呵护,为家人筑牢健康屏障,远离霉菌带来的伤害。
参考资料:
[1]浙江之声《6岁女孩发烧17天,脑子被“啃”出十几个洞,差点被“啃空”!医生:“真凶”很常见》
[2]生命时报《家里一旦出现这种小霉点,身体多个部位要遭殃》
[3]福建卫生报《女孩脑子被“啃”出十几个洞,再迟点就“啃空”了!医生:元凶很常见!你家可能也有》
[4]重庆广电第1眼《6岁女孩吸入霉菌,脑内出现十几个洞,家里这种情况要注意!》